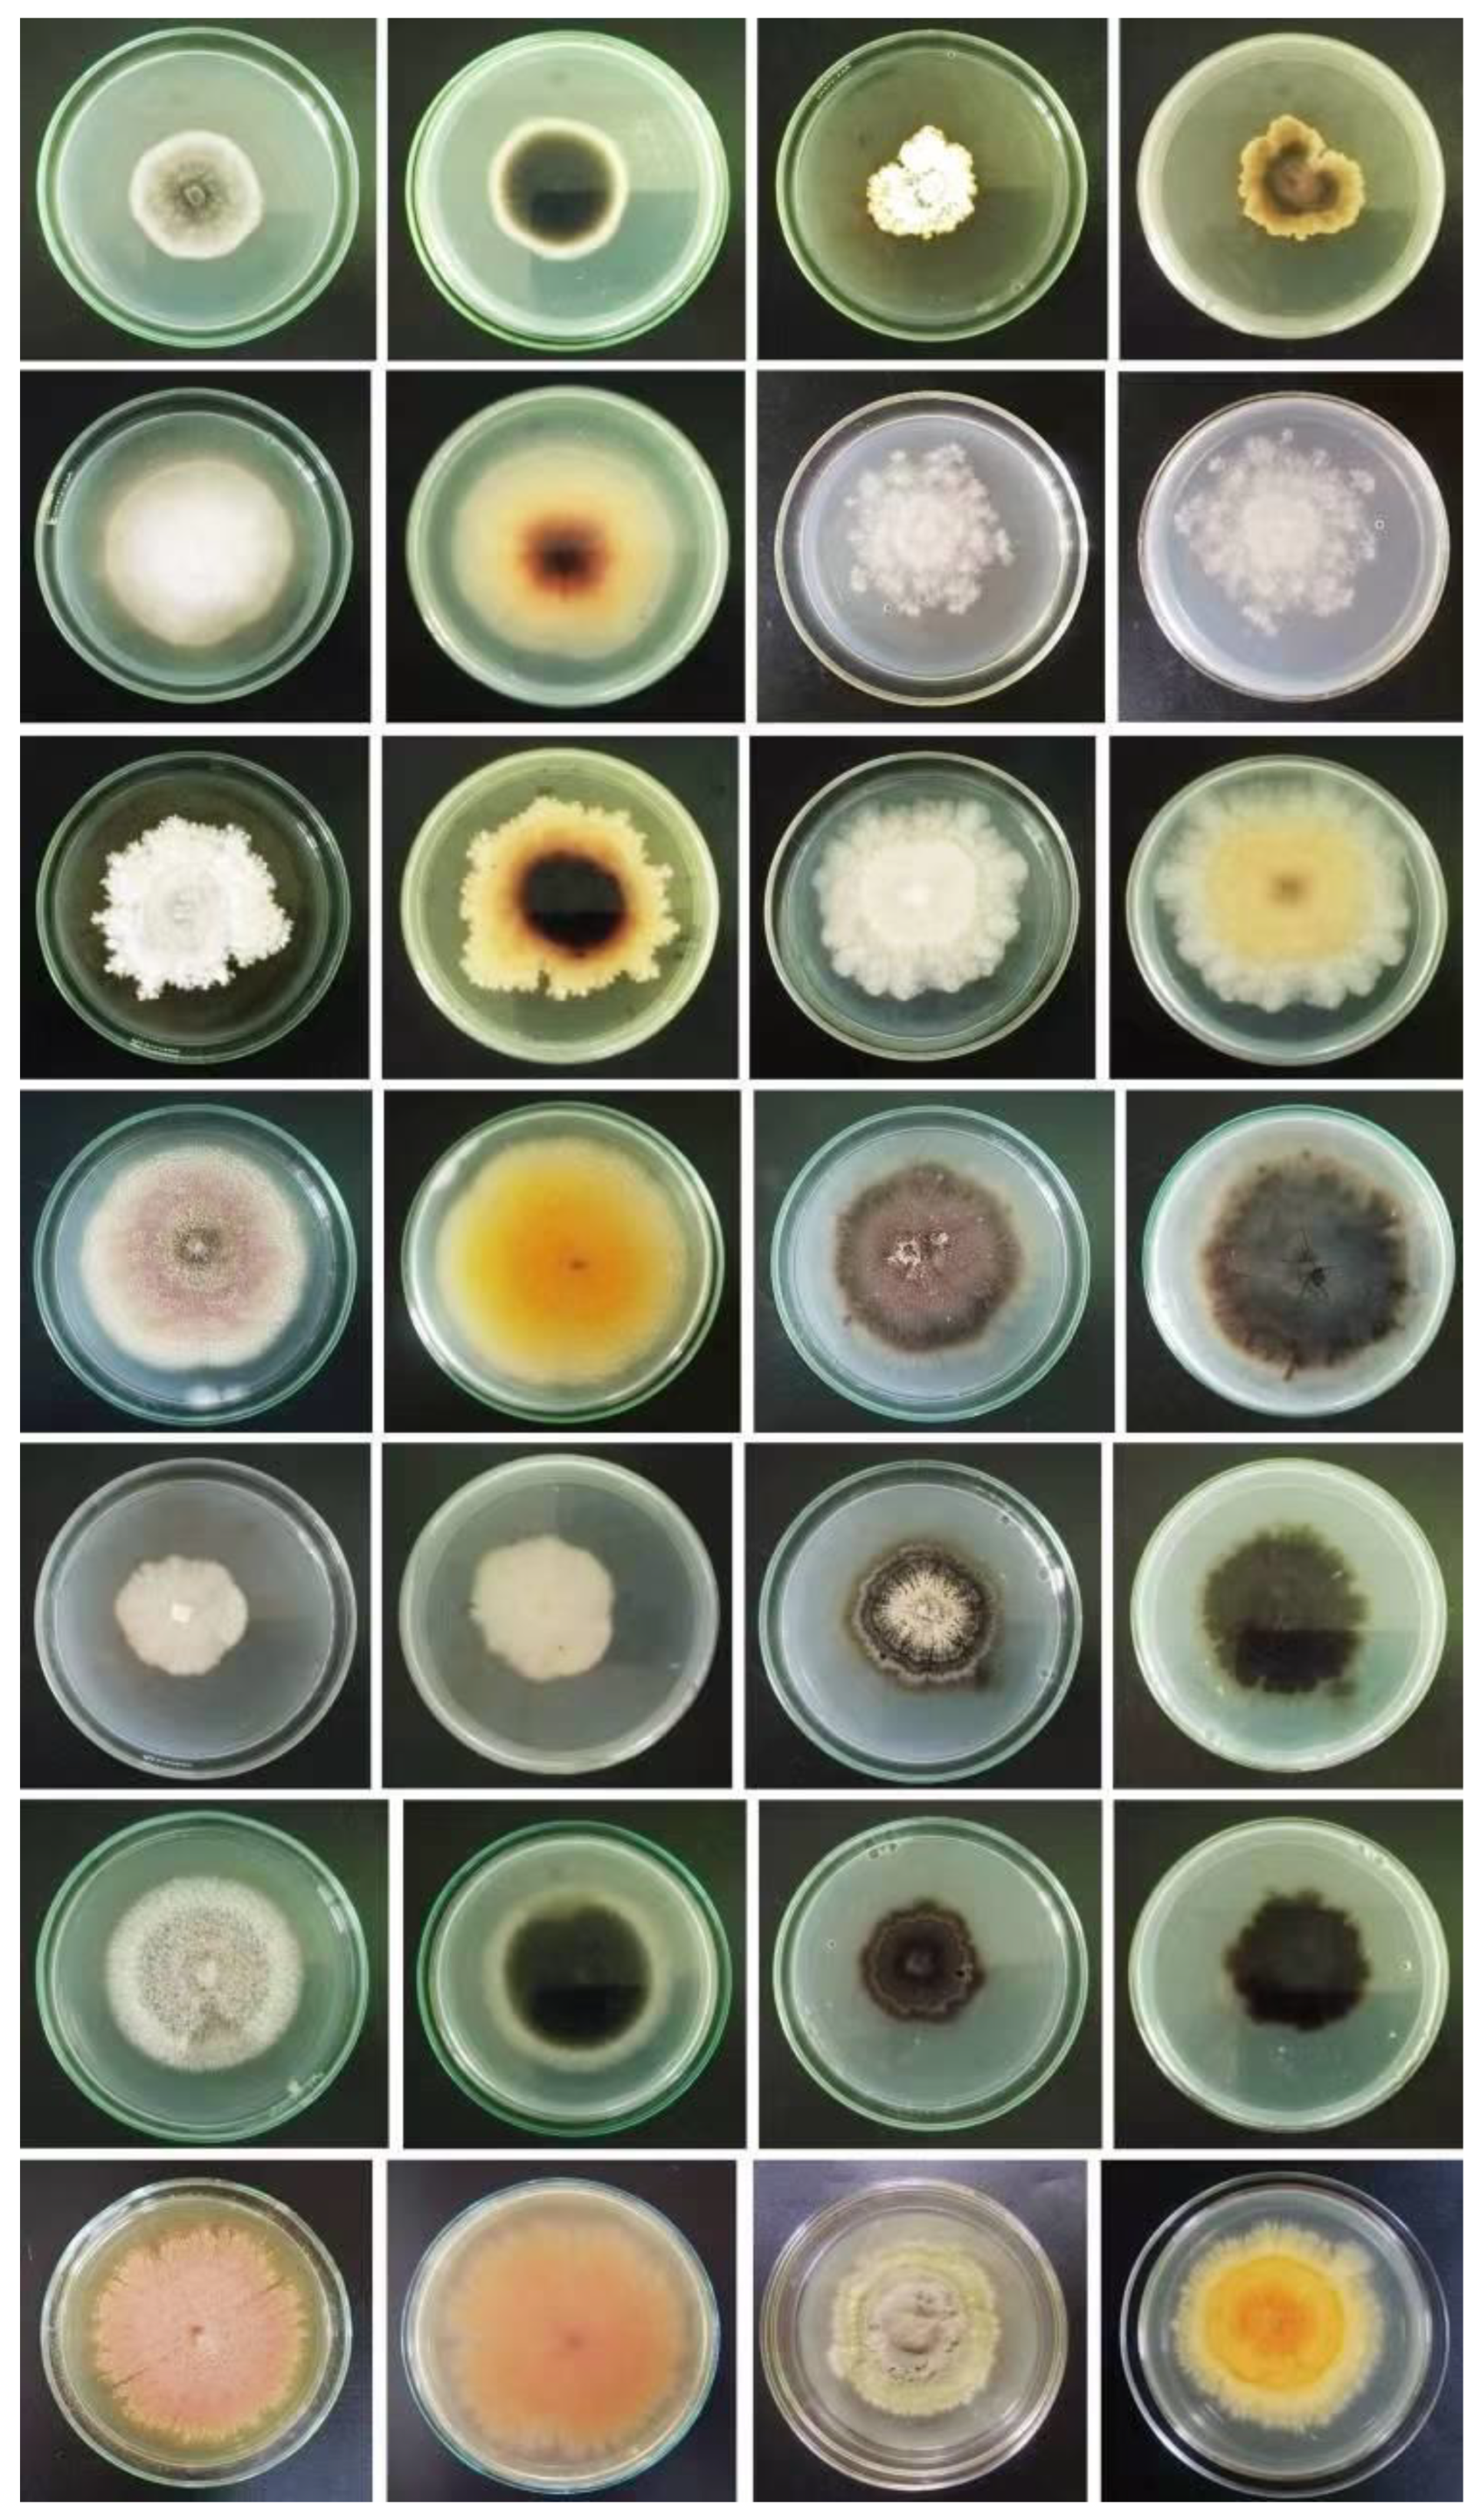
Jof 08 01141 g007 Jof 08 01141 g007

Ecological and Oceanographic Perspectives in Future Marine Fungal Taxonomy
Abstract
1. Introduction
2. Coastal, Semi-Marine, and Marine Habitats—How Can They Be Defined?
2.1. Saline Lakes: Are They Marine Ecosystems?
2.2. Coastal Upwelling, Oceanic Currents, and Nutrient-Rich Areas
2.3. Relationships with Oceanic Current: What Are the Extensively Studied Fungal Habitats and Existing Habitats?
2.4. Upwelling
2.5. Major Upwelling Systems with Extensive Studies of Marine Fungi
2.6. Major Upwelling Systems Understudied for Marine Fungi
2.7. Poorly Studied Regions with Great Potential for Improving Fungal Studies
2.8. Advancement of Technology to Detect Fungi Inhabiting Extreme Ecosystems
2.8.1. Ecological Sampling and HTS as a Tool of Integrated Sciences
2.8.2. HTS Studies of Extreme Marine Habitats
| Reference | Location/Habitat | HTS Method (NGS Platform) | Total OTUs/ASVs | % of Unassigned Fungi |
|---|---|---|---|---|
| [195] | Antarctic | Miseq | 263 ASVs | 27.78% |
| [203] | South China Sea | llumina | 1272 OTUs | 8.96% |
| [198] | whale fall | IonTorrent | 107 OTUs | 37% |
| [204] | Magellan seamounts | HiSeq | 1662 OTUs | 34.70% |
| [205] | Magellan seamounts | Miseq | 1979 OTUs | 27.03% |
| [169] | Yap Trench | llumina | 890 OTUs | 80% |
| [206] | Gulf of Mexico | Miseq | 4421 OTUs | 19.29% |
| [207] | Mariana Trench | HiSeq | 91 OTUs | 0.04% |
| [52] | hydrothermal vent | Hiseq | 723 OTUs | 37.67% |
| [197] | canyons of the Mediterranean Sea | Miseq | 1742 OTUs | 64% |
| [166] | asphalt seeps | IonTorrent | 113 OTUs | 14.20% |
| [32] | the Southwest India Ridge | Miseq | 250–300 OTUs | 0.02% |
| [32] | Okinawa trough | Miseq | 439 OTUs | 2.40% |
2.8.3. Metabolomics and Its Importance in Chemotaxonomy and Discovering Novel Compounds
2.9. Overlooked Habitats and Regions of Marine Fungi
2.10. Concluding Remarks
Supplementary Materials
Author Contributions
Funding
Institutional Review Board Statement
Informed Consent Statement
Data Availability Statement
Acknowledgments
Conflicts of Interest
References
- Naranjo-Ortiz, M.A.; Gabaldόn, T. Fungal evolution: Major ecological adaptations and evolutionary transitions. Biol. Rev. 2019, 94, 1443–1476. [Google Scholar] [CrossRef] [PubMed]
- Hawksworth, D.L.; Lücking, R. Fungal diversity revisited: 2.2 to 3.8 million species. Microbiol. Spectrum. 2017, 5, 2–2016. [Google Scholar] [CrossRef] [PubMed]
- Hawksworth, D.L. The magnitude of fungal diversity: The 1.5 million species estimate revisited. Mycol. Res. 2001, 105, 1422–1432. [Google Scholar] [CrossRef]
- Lücking, R.; Aime, M.C.; Robbertse, B.; Miller, A.N.; Ariyawansa, H.A.; Aoki, T.; Cardinali, G.; Crous, P.W.; Druzhinina, I.S.; Geiser, D.M.; et al. Unambiguous identification of fungi: Where do we stand and how accurate and precise is fungal DNA barcoding? IMA Fungus 2020, 11, 14. [Google Scholar] [CrossRef] [PubMed]
- Phukhamsakda, C.; Nilsson, R.H.; Bhunjun, C.S.; de Farias, A.R.G.; Sun, Y.R.; Wijesinghe, S.N.; Raza, M.; Bao, D.F.; Lu, L.; Tibpromma, S.; et al. The numbers of fungi: Contributions from traditional taxonomic studies and challenges of metabarcoding. Fungal Divers. 2022, 114, 327–386. [Google Scholar] [CrossRef]
- Quaedvlieg, W.; Binder, M.; Groenewald, J.; Summerell, B.; Carnegie, A.; Burgess, T.; Crous, P. Introducing the Consolidated Species Concept to resolve species in the Teratosphaeriaceae. Pers. Mol. Phylogeny Evol. Fungi 2014, 33, 1–40. [Google Scholar] [CrossRef]
- Jones, E.B.G. Fifty Years of Marine Mycology. Fungal Divers. 2011, 50, 73–112. [Google Scholar] [CrossRef]
- Fryar, S.C.; Hyde, K.D.; Catcheside, D.E.A. A survey of marine fungi on wood in South Australia. Bot. Mar. 2020, 63, 469–478. [Google Scholar] [CrossRef]
- Gozari, M.; Alborz, M.; El-Seedi, H.R.; Jassbi, A.R. Chemistry, biosynthesis and biological activity of terpenoids and meroterpenoids in bacteria and fungi isolated from different marine habitats. Eur. J. Med. Chem. 2021, 210, 112957. [Google Scholar] [CrossRef]
- Pang, K.L.; Overy, D.P.; Jones, E.B.G.; da Luz Calado, M.; Burgaud, G.; Walker, A.K.; Johnson, J.A.; Kerr, R.G.; Cha, H.J.; Bills, G.F. “Marine fungi” and “marine-derived fungi” in natural product chemistry research: Toward a new consensual definition. Fungal Biol. Rev. 2016, 30, 163–175. [Google Scholar] [CrossRef]
- Johnson, T.W.; Sparrow, F.K. Fungi in Oceans and Estuaries; Hafner Publishing: New York, NY, USA, 1961; pp. 1–668. [Google Scholar]
- Tubaki, K. Studies on the Japanese marine fungi lignincolous group (III), algicolous group and a general consideration. Publ. Seto Mar. Biol. Lab. 1968, 15, 357–372. [Google Scholar] [CrossRef][Green Version]
- Jones, E.B.G.; Pang, K.L.; Abdel-Wahab, M.A.; Scholz, B.; Hyde, K.D.; Boekhout, T.; Ebel, R.; Rateb, M.E.; Henderson, L.; Sakayaroj, J.; et al. An online resource for marine fungi. Fungal Divers. 2019, 96, 347–433. [Google Scholar] [CrossRef]
- Jones, E.B.G.; Moss, S.T. Ascospore appendages of marine ascomycetes: An evaluation of appendages as taxonomic criteria. Mar. Biol. 1978, 49, 11–26. [Google Scholar] [CrossRef]
- Jones, E.B. Ultrastructure and taxonomy of the aquatic ascomycetous order Halosphaeriales. Can. J. Bot. 1995, 73, 790–801. [Google Scholar] [CrossRef]
- Jones, E.B.G.; Sakayaroj, J.; Suetrong, S.; Somrithipol, S.; Pang, K.L. Classification of marine Ascomycota, anamorphic taxa and Basidiomycota. Fungal Divers. 2009, 35, 187. [Google Scholar]
- Suetrong, S.; Schoch, C.L.; Spatafora, J.W.; Kohlmeyer, J.; Jones, E.B.G. Molecular systematics of the marine Dothideomycetes. Stud. Mycol. 2009, 64, 155–173. [Google Scholar] [CrossRef]
- Sakayaroj, J.; Pang, K.L.; Jones, E.G. Multi-gene phylogeny of the Halosphaeriaceae: Its ordinal status, relationships between genera and morphological character evolution. Fungal Divers. 2011, 46, 87–109. [Google Scholar] [CrossRef]
- Sakayaroj, J.; Supaphon, O.; Jones, E.B.G.; Phongpaichit, S. Diversity of higher marine fungi at Hat Khanom-Mu Ko Thale Tai National Park, Southern Thailand. Songklanakarin J. Sci. Technol. 2011, 33, 15–22. [Google Scholar]
- Spatafora, J.; Volkmann-Kohlmeyer, B.; Kohlmeyer, J. Independent terrestrial origins of the Halosphaeriales (marine Ascomycota). Am. J. Bot. 1998, 85, 1569–1580. [Google Scholar] [CrossRef]
- Zuccaro, A.; Schulz, B.; Mitchell, J.I. Molecular detection of ascomycetes associated with Fucus serratus. Mycol. Res. 2003, 107, 1451–1466. [Google Scholar] [CrossRef]
- Zuccaro, A.; Schoch, C.L.; Spatafora, J.W.; Kohlmeyer, J.; Draeger, S.; Mitchell, J.I. Detection and identification of fungi intimately associated with the brown seaweed Fucus serratus. Appl. Environ. Microbiol. 2008, 74, 931–941. [Google Scholar] [CrossRef] [PubMed]
- Jones, E.B.G.; Pang, K.L.; Stanley, S.J. Fungi from Marine Algae. In Marine and Fungal-Like Organisms; Jones, E.G.B., Pang, K.L., Eds.; Walter de Gruyter: Berlin, Germany, 2012; pp. 329–344. [Google Scholar]
- Jones, E.B.G. Are there more marine fungi to be described? Bot. Mar. 2011, 54, 343–354. [Google Scholar] [CrossRef]
- Jones, E.B.G.; Suetrong, S.; Sakayaroj, J.; Bahkali, A.H.; Abdel-Wahab, M.A.; Boekhout, T.; Pang, K.L. Classification of marine Ascomycota, Basidiomycota, Blastocladiomycota and Chytridiomycota. Fungal Divers. 2015, 73, 1–72. [Google Scholar] [CrossRef]
- Jones, E.B.G.; Devadatha, B.; Abdel-Wahab, M.A.; Dayarathne, M.C.; Zhang, S.N.; Hyde, K.D.; Liu, J.K.; Bahkali, A.H.; Sarma, V.V.; Tibell, S.; et al. Phylogeny of new marine Dothideomycetes and Sordariomycetes from mangroves and deep-sea sediments. Bot. Mar. 2020, 63, 155–181. [Google Scholar] [CrossRef]
- Amend, A.; Burgaud, G.; Cunliffe, M.; Edgcomb, V.P.; Ettinger, C.L.; Gutiérrez, M.H.; Heitman, J.; Hom, E.F.; Ianiri, G.; Jones, A.C.; et al. Fungi in the marine environment: Open questions and unsolved problems. MBio 2019, 10, e01189-18. [Google Scholar] [CrossRef]
- Dayarathne, M.C.; Jones, E.B.; Maharachchikumbura, S.S.; Devadatha, B.; Sarma, V.V.; Khongphinitbunjong, K.; Chomnunti, P.; Hyde, K.D. Morpho-molecular characterization of microfungi associated with marine based habitats. Mycosphere 2020, 11, 1–88. [Google Scholar] [CrossRef]
- Fell, J.W.; Statzell-Tallman, A.; Scorzetti, G.; Gutie´rrez, M.H. Five new species of yeasts from fresh water and marine habitats in the Florida Everglades. Antonie Leeuwenhoek 2011, 99, 533–549. [Google Scholar] [CrossRef]
- Ramesh, T.; Yamunadevi, R.; Sundaramanickam, A.; Thangaraj, M.; Kumaran, R.; Annadurai, D. Biodiversity of the Fungi in Extreme Marine Environments. In Fungi Bio-Prospects in Sustainable Agriculture, Environment and Nano-Technology; Academic Press: Cambridge, MA, USA, 2021; pp. 75–100. [Google Scholar] [CrossRef]
- Tejesvi, M.V.; Ruotsalainen, A.L.; Markkola, A.M.; Pirttilä, A.M. Root endophytes along a primary succession gradient in northern Finland. Fungal Divers. 2010, 41, 125–134. [Google Scholar] [CrossRef]
- Zhang, X.; Wang, G.; Xu, X.; Nong, X.; Wang, J.; Amin, M.; Qi, S. Exploring fungal diversity in deep-sea sediments from Okinawa Trough using high-throughput Illumina sequencing. Deep Sea Res. Part I 2016, 116, 99–105. [Google Scholar] [CrossRef]
- Mitchell, J.I.; Zuccaro, A. Sequences, the environment and fungi. Mycologist 2006, 20, 62–74. [Google Scholar] [CrossRef]
- Seifert, K.A. Progress towards DNA barcoding of fungi. Mol. Ecol. Resour. 2009, 9, 83–89. [Google Scholar] [CrossRef] [PubMed]
- Parr, C.S.; Guralnick, R.; Cellinese, N.; Page, R. Evolutionary informatics: Unifying knowledge about the diversity of life. Trends Ecol. Evol. 2012, 27, 94–103. [Google Scholar] [CrossRef] [PubMed]
- Grossart, H.-P.; Wurzbacher, C.; James, T.Y.; Kagami, M. Discovery of dark matter fungi in aquatic ecosystems demands a reappraisal of the phylogeny and ecology of zoosporic fungi. Fungal Ecol. 2016, 19, 28–38. [Google Scholar] [CrossRef]
- Page, R.D.M. DNA barcoding and taxonomy: Dark taxa and dark texts. Philos. Trans. R. Soc. B Biol. Sci. 2016, 371, 20150334. [Google Scholar] [CrossRef] [PubMed]
- Tedersoo, L.; Smith, M.E. Ectomycorrhizal Fungal Lineages: Detection of Four New Groups and Notes on Consistent Recognition of Ectomycorrhizal Taxa in High-Throughput Sequencing Studies. In Biogeography of Mycorrhizal Symbiosis; Springer: Cham, Switzerland, 2017; pp. 125–142. [Google Scholar] [CrossRef]
- Ryberg, M.; Nilsson, R.H. New light on names and naming of dark taxa. MycoKeys 2018, 30, 31–39. [Google Scholar] [CrossRef] [PubMed]
- Lücking, R.; Hawksworth, D.L. Formal description of sequence-based voucherless Fungi: Promises and pitfalls, and how to resolve them. IMA Fungus 2018, 9, 143–165. [Google Scholar] [CrossRef]
- Gao, Z.; Li, B.; Zheng, C.; Wang, G. Molecular detection of fungal communities in the Hawaiian marine sponges Suberites zeteki and Mycale armata. Appl. Environ. Microbiol. 2008, 74, 6091–6101. [Google Scholar] [CrossRef]
- Limtong, S.; Yongmanitchai, W. Candida chanthaburiensis sp. nov., Candida kungkrabaensis sp. nov. and Candida suratensis sp. nov., three novel yeast species from decaying plant materials submerged in water of mangrove forests. Antonie Leeuwenhoek 2010, 98, 379–388. [Google Scholar] [CrossRef]
- Statzell-Tallman, A.; Scorzetti, G.; Fell, J.W. Candida spencermartinsiae sp. nov., Candida taylorii sp. nov. and Pseudozyma abaconensis sp. nov., novel yeasts from mangrove and coral reef ecosystems. Int. J. Syst. Evol. Microbiol. 2010, 60, 1978–1984. [Google Scholar] [CrossRef]
- Sutani, A.; Ueno, M.; Nakagawa, S.; Sawayama, S. Melon aroma-producing yeast isolated from coastal marine sediment in maizuru bay, japan. Fish. Sci. 2015, 81, 929–936. [Google Scholar] [CrossRef][Green Version]
- Cheng, X.; Li, W.; Cai, L. Molecular phylogeny of Ascotricha, including two new marine algae-associated species. Mycologia 2015, 107, 490–504. [Google Scholar] [CrossRef] [PubMed]
- Gnavi, G.; Garzoli, L.; Poli, A.; Prigione, V.; Burgaud, G.; Varese, G.C. The culturable mycobiota of Flabellia petiolata: First survey of marine fungi associated to a Mediterranean green alga. PLoS ONE 2017, 12, e0175941. [Google Scholar] [CrossRef] [PubMed]
- Bovio, E.; Garzoli, L.; Poli, A.; Prigione, V.; Firsova, D.; McCormack, G.P.; Varese, G.C. The culturable mycobiota associated with three Atlantic sponges, including two new species: Thelebolus balaustiformis and T. spongiae. Fungal Syst. Evol. 2018, 1, 141–167. [Google Scholar] [CrossRef] [PubMed]
- Devadatha, B.; Sarma, V.V. Pontoporeia mangrovei sp. nov, a new marine fungus from an Indian mangrove along with a new geographical and host record of Falciformispora lignatilis. Curr. Res. Environ. Appl. Mycol. 2018, 8, 238–246. [Google Scholar] [CrossRef]
- Garzoli, L.; Poli, A.; Prigione, V.; Gnavi, G.; Varese, G.C. Peacock’s tail with a fungal cocktail: First assessment of the mycobiota associated with the brown alga Padina pavonica. Fungal Ecol. 2018, 35, 87–97. [Google Scholar] [CrossRef]
- Zhang, S.N.; Abdel-Wahab, M.A.; Jones, E.G.; Hyde, K.D.; Liu, J.K.J. Additions to the genus Savoryella (Savoryellaceae), with the asexual morphs Savoryella nypae comb. nov. and S. sarushimana sp. nov. Phytotaxa 2019, 408, 195–207. [Google Scholar] [CrossRef]
- Romão, D.; Staley, C.; Ferreira, F.; Rodrigues, R.; Sabino, R.; Veríssimo, C.; Wang, P.; Sadowsky, M.; Brandão, J. Next-generation sequencing and culture-based techniques offer complementary insights into fungi and prokaryotes in beach sands. Mar. Pollut. Bull. 2017, 119, 351–358. [Google Scholar] [CrossRef]
- Xu, W.; Gong, L.F.; Pang, K.L.; Luo, Z.H. Fungal diversity in deep-sea sediments of a hydrothermal vent system in the Southwest Indian Ridge. Deep-Sea Res. Part I 2018, 131, 16–26. [Google Scholar] [CrossRef]
- Pham, T.T.; Dinh, K.V.; Nguyen, V.D. Biodiversity and enzyme activity of marine fungi with 28 new records from the tropical coastal ecosystems in Vietnam. Mycobiology 2021, 49, 559–581. [Google Scholar] [CrossRef]
- Zhu, D.; Sethupathy, S.; Gao, L.; Nawaz, M.Z.; Zhang, W.; Jiang, J.; Sun, J. Microbial diversity and community structure in deep-sea sediments of south Indian ocean. Environ. Sci. Pollut. R. 2022, 29, 45793–45807. [Google Scholar] [CrossRef]
- Gray, J.S.; Elliott, M. Ecology of Marine Sediments: From Science to Management; Oxford University Press: Oxford, UK, 2009. [Google Scholar]
- Cochrane, S.K.J.; Andersen, J.H.; Berg, T.; Blanchet, H.; Borja, A.; Carstensen, J.; Elliott, M.; Hummel, H.; Niquil, N.; Renaud, P.E. What Is Marine Biodiversity? Towards Common Concepts and Their Implications for Assessing Biodiversity Status. Front. Mar. Sci. 2016, 3, 248. [Google Scholar] [CrossRef]
- Hays, G.C. Ocean currents and marine life. Curr. Biol. 2017, 27, 470–473. [Google Scholar] [CrossRef] [PubMed]
- Xu, Z.; Li, Y.; Lu, Y.; Li, Y.; Yuan, Z.; Dai, M.; Liu, H. Impacts of the Zhe-Min Coastal Current on the biogeographic pattern of microbial eukaryotic communities. Prog. Oceanogr. 2020, 183, 102309. [Google Scholar] [CrossRef]
- Dalpadado, P.; Arrigo, K.R.; van Dijken, G.L.; Gunasekara, S.S.; Ostrowski, M.; Bianchi, G.; Sperfeld, E. Warming of the Indian Ocean and its impact on temporal and spatial dynamics of primary production. Prog. Oceanogr. 2021, 198, 102688. [Google Scholar] [CrossRef]
- Young, J.W.; Hunt, B.P.V.; Cook, T.R.; Llopiz, J.K.; Hazen, E.L.; Pethybridge, H.R.; Ceccarelli, D.; Lorrain, A.; Robert, J.O.; Allain, V.; et al. The trophodynamics of marine top predators: Current knowledge, recent advances and challenges. Deep. Sea Res. Part II Top. Stud. Oceanogr. 2015, 113, 170–187. [Google Scholar] [CrossRef]
- Jayasinghe, R.P.P.K.; Amarasinghe, U.S.; Newton, A. Evaluation of status of commercial fish stocks in European marine subareas using mean trophic levels of fish landings and spawning stock biomass. Ocean Coast. Manag. 2017, 143, 154–163. [Google Scholar] [CrossRef][Green Version]
- Miloslavich, P.; Klein, E.; Díaz, J.M.; Hernandez, C.E.; Bigatti, G.; Bigatti, G.; Campos, L.; Artigas, F.; Castillo, J.; Penchaszadeh, P.E.; et al. MarineBiodiversity in the Atlantic and Pacific Coasts of South America: Knowledge and Gaps. PLoS ONE 2011, 6, e14631. [Google Scholar] [CrossRef]
- O’Dor, R.; Miloslavich, P.; Yarincik, K. Marine Biodiversity and Biogeography—Regional Comparisons of Global Issues, an Introduction. PLoS ONE 2010, 5, e11871. [Google Scholar] [CrossRef]
- Costello, M.J.; Chaudhary, C. Marine Biodiversity, Biogeography, Deep-Sea Gradients, and Conservation. Curr. Biol. 2017, 27, 511–527. [Google Scholar] [CrossRef]
- Badgley, C.; Smiley, T.M.; Terry, R.; Davis, E.B.; DeSantis, L.R.G.; Fox, D.F.; Hopkins, S.S.B.; Jezkova, T.; Matocq, M.D.; Matzke, N.; et al. Biodiversity and Topographic Complexity: Modern and Geohistorical Perspectives. Trends Oceanogr. Evol. 2017, 32, 211–226. [Google Scholar] [CrossRef]
- Costa, I.P.; Maia, L.C.; Cavalcanti, M.A. Diversity of leaf endophytic fungi in mangrove plants of northeast Brazil. Braz. J. Microbiol. 2012, 43, 1165–1173. [Google Scholar] [CrossRef]
- Abdel-Gawad, K.M.; Hifney, A.F.; Issa, A.A.; Gomaa, M. Spatio-temporal, environmental factors, and host identity shape culturable-epibiotic fungi of seaweeds in the Red Sea, Egypt. Hydrobiologia 2014, 740, 37–49. [Google Scholar] [CrossRef]
- Venkatachalam, A.; Govinda Rajulu, M.B.; Thirunavukkarasu, N.; Suryanarayanan, T.S. Endophytic fungi of marine algae and seagrasses: A novel source of chitin modifying enzymes. Mycosphere 2015, 6, 345–355. [Google Scholar] [CrossRef]
- Hyde, K.D.; Jones, E.B.G.; Leaño, E.; Pointing, S.B.; Poonyth, A.D.; Vrijmoed, L.L.P. Role of fungi in marine ecosystems. Biodivers. Conserv. 1998, 7, 1147–1161. [Google Scholar] [CrossRef]
- Bianchi, T.S.; Cui, X.; Blair, N.E.; Burdige, D.J.; Eglinton, T.I.; Galy, V. Centers of organic carbon burial and oxidation at the land-ocean interface. Org. Geochem. 2018, 115, 138–155. [Google Scholar] [CrossRef]
- Selway, C.A.; Armbrecht, L.; Thornalley, D. An outlook for the acquisition of marine sedimentary ancient DNA (sedaDNA) from north Atlantic Ocean archive material. Paleoceanogr. Paleoclimatol. 2022, 37, e2021PA004372. [Google Scholar] [CrossRef]
- Hanski, I. Habitat, Loss, the Dynamics of Biodiversity, and a Perspective on Conservation. AMBIO 2011, 40, 248–255. [Google Scholar] [CrossRef] [PubMed]
- Calabon, M.S.; Jones, E.B.G.; Hyde, K.D.; Boonmee, S.; Tibell, S.; Tibell, L.; Pang, K.L.; Phookamsak, R. Phylogenetic assessment and taxonomic revision of Halobyssothecium and Lentithecium (Lentitheciaceae, Pleosporales). Mycol. Prog. 2021, 20, 701–720. [Google Scholar] [CrossRef]
- Calabon, M.S.; Jones, E.B.; Promputtha, I.; Hyde, K.D. Fungal Biodiversity in Salt Marsh Ecosystems. J. Fungi 2021, 7, 648. [Google Scholar] [CrossRef]
- Ponder, W.I.; Hutchings, P.; Chapman, R.E. Overview of the Conservation of Australian Marine Invertebrates—A Report for Environment Australia; Australian Museum: Sydney, Australian, 2002; pp. 1–487. [Google Scholar]
- Balasuriya, A. Coastal Area Management: Biodiversity and Ecological Sustainability in Sri Lankan Perspective. In Biodiversity and Climate Change Adaptation in Tropical Islands; Academic Press: Cambridge, MA, USA, 2018; pp. 701–724. [Google Scholar] [CrossRef]
- de Juan, S.; Hewitt, J. Relative importance of local biotic and environmental factors versus regional factors in driving macrobenthic species richness in intertidal areas. Mar. Ecol. Prog. Ser. 2011, 423, 117–129. [Google Scholar] [CrossRef][Green Version]
- Short, A.D. Coastal Processes and Beaches. Nat. Educ. Knowl. 2012, 3, 15. [Google Scholar]
- Befus, K.M.; Cardenas, M.B.; Erler, D.V.; Santos, I.R.; Eyre, B.D. Heat transport dynamics at a sandy intertidal zone. Water Resour. Res. 2013, 49, 3770–3786. [Google Scholar] [CrossRef]
- Raghukumar, S. Fungi in Coastal and Oceanic Marine Ecosystems; Springer: New York, NY, USA, 2017; pp. 1–343. [Google Scholar]
- Arzanlou, M.; Samadi, R.; Frisvad, J.C.; Houbraken, J.; Ghosta, Y. Two novel Aspergillus species from hypersaline soils of the National Park of Lake Urmia, Iran. Mycol. Prog. 2016, 15, 1081–1092. [Google Scholar] [CrossRef][Green Version]
- Hyde, K.D.; Hongsanan, S.; Jeewon, R.; Bhat, D.J.; McKenzie, E.H.C.; Jones, E.B.G.; Phookamsak, R.; Ariyawansa, H.A.; Boonmee, S.; Zhao, Q.; et al. Fungal diversity notes 367–491: Taxonomic and phylogenetic contributions to fungal taxa. Fungal Divers. 2016, 80, 1–270. [Google Scholar] [CrossRef]
- Crous, P.W.; Wingfield, M.J.; Schumacher, R.K.; Summerell, B.A.; Giraldo, A.; Gené, J.; Guarro, J.; Wanasinghe, D.N.; Hyde, K.D.; Camporesi, E.; et al. Fungal Planet description sheets: 281–319. Persoonia 2014, 33, 212–289. [Google Scholar] [CrossRef]
- Papizadeh, M.; Wijayawardene, N.N.; Amoozegar, M.A.; Saba, F.; Fazeli, S.A.; Hyde, K.D. Neocamarosporium jorjanensis, N. persepolisi, and N. solicola spp. nov. (Neocamarosporiaceae, Pleosporales) isolated from saline lakes of Iran indicate the possible halotolerant nature for the genus. Mycol. Prog. 2018, 17, 661–679. [Google Scholar] [CrossRef]
- Wiley, E.O. Vicariance biogeography. Annu. Rev. Ecol. Syst. 1988, 19, 513–542. [Google Scholar] [CrossRef]
- Gall, S.C.; Thompson, R.C. The impact of debris on marine life. Mar. pollut. Bull. 2015, 92, 170–179. [Google Scholar] [CrossRef]
- Darby, D.A.; Ortiz, J.; Polyak, L.; Lund, S.; Jakobsson, M.; Woodgate, R.A. The role of currents and sea ice in both slowly deposited central Arctic and rapidly deposited Chukchi–Alaskan margin sediments. Glob. Planet. Change 2009, 68, 58–72. [Google Scholar] [CrossRef]
- Hamdan, L.J.; Coffin, R.B.; Sikaroodi, M.; Greinert, J.; Treude, T.; Gillevet, P.M. Ocean currents shape the microbiome of Arctic marine sediments. ISME J. 2013, 7, 685–696. [Google Scholar] [CrossRef]
- Samonds, K.E.; Godfrey, L.R.; Ali, J.R.; Goodman, S.M.; Vences, M.; Sutherland, M.R.; Irwin, M.T.; Krause, D.W. Spatial and temporal arrival patterns of Madagascar’s vertebrate fauna explained by distance, ocean currents, and ancestor type. Proc. Natl. Acad. Sci. USA 2012, 109, 5352–5357. [Google Scholar] [CrossRef] [PubMed]
- Hu, Z.M.; Zhang, J.; Lopez-Bautista, J.; Duan, D.L. Asymmetric genetic exchange in the brown seaweed Sargassum fusiforme (Phaeophyceae) driven by oceanic currents. Mar. Biol. 2013, 160, 1407–1414. [Google Scholar] [CrossRef]
- Nakajima, Y.; Matsuki, Y.; Lian, C.L.; Fortes, M.D.; Uy, W.H.; Campos, W.L.; Nakaoka, M.; Nadaoka, K. The Kuroshio current influences genetic diversity and population genetic structure of a tropical seagrass, Enhalus acoroides. Mol. Ecol. 2014, 23, 6029–6044. [Google Scholar] [CrossRef] [PubMed]
- Geng, Q.; Wang, Z.; Tao, J.; Kimura, M.K.; Liu, H.; Hogetsu, T.; Lian, C. Ocean Currents Drove Genetic Structure of Seven Dominant Mangrove Species Along the Coastlines of Southern China. Front. Genet. 2021, 12, 615911. [Google Scholar] [CrossRef] [PubMed]
- Muhling, B.A.; Brodie, S.; Smith, J.A.; Tommasi, D.; Gaitan, C.F.; Hazen, E.L.; Jacox, M.G.; Auth, T.D.; Brodeur, R.D. Predictability of Species Distributions Deteriorates Under Novel Environmental Conditions in the California Current System. Front. Mar. Sci. 2020, 7, 589. [Google Scholar] [CrossRef]
- Brum, J.R.; Ignacio-Espinoza, J.C.; Roux, S.; Doulcier, G.; Acinas, S.G.; Alberti, A.; Gorsky, G. Patterns and ecological drivers of ocean viral communities. Science 2015, 348, 1261498. [Google Scholar] [CrossRef]
- Gibbons, S.M.; Caporaso, J.G.; Pirrung, M.; Field, D.; Knight, R.; Gilbert, J.A. Evidence for a persistent microbial seed bank throughout the global ocean. Proc. Natl. Acad. Sci. USA 2013, 110, 4651–4655. [Google Scholar] [CrossRef] [PubMed]
- Livermore, J.A.; Jones, S.E. Local-global overlap in diversity informs mechanisms of bacterial biogeography. ISME J. 2015, 9, 2413–2422. [Google Scholar] [CrossRef]
- Li, W.; Wang, M.; Pan, H.; Burgaud, G.; Liang, S.; Guo, J.; Luo, T.; Li, Z.; Zhang, S.; Cai, L. Highlighting patterns of fungal diversity and composition shaped by ocean currents using the East China Sea as a model. Mol. Ecol. 2018, 27, 564–576. [Google Scholar] [CrossRef]
- Doblin, M.A.; van Sebille, E. Drift in ocean currents impacts intergenerational microbial exposure to temperature. Proc. Natl. Acad. Sci. USA 2016, 113, 5700–5705. [Google Scholar] [CrossRef] [PubMed]
- Richards, T.A.; Leonard, G.; Mahe, F.; Del Campo, J.; Romac, S.; Jones, M.D.; Maguire, F.; Dunthorn, M.; De Vargas, C.; Massana, R.; et al. Molecular diversity and distribution of marine fungi across 130 European environmental samples. Proc. Biol. Sci. 2015, 282, 20152243. [Google Scholar] [CrossRef]
- Suursaar, Ü. Combined impact of summer heat waves and coastal upwelling in the baltic sea. Oceanologia 2020, 62, 511–524. [Google Scholar] [CrossRef]
- Wilson, L.J.; Fulton, C.J.; Hogg, A.M.; Joyce, K.E.; Radford, B.T.; Fraser, C.I. Climate-driven changes to ocean circulation and their inferred impacts on marine dispersal patterns. Glob. Ecol. Biogeogr. 2016, 25, 923–939. [Google Scholar] [CrossRef]
- Oke, P.R.; England, M.H. Oceanic response to changes in the latitude of the Southern Hemisphere subpolar westerly winds. J. Clim. 2004, 17, 1040–1054. [Google Scholar] [CrossRef]
- Cai, W. Antarctic ozone depletion causes an intensification of the Southern Ocean super-gyre circulation. Geophys. Res. Lett. 2006, 33, 3. [Google Scholar] [CrossRef]
- Roemmich, D.; Gilson, J.; Davis, R.; Sutton, P.; Wijffels, S.; Riser, S. Decadal spin up of the South Pacific subtropical gyre. J. Phys. Oceanogr. 2007, 37, 162–173. [Google Scholar] [CrossRef]
- Luo, Y.; Rothstein, L.M. Response of the Pacific Ocean circulation to climate change. Atmos. Ocean 2011, 49, 235–244. [Google Scholar] [CrossRef]
- Sorte, C.J. Predicting persistence in a changing climate: Flow direction and limitations to redistribution. Oikos 2013, 122, 161–170. [Google Scholar] [CrossRef]
- Stewart, R.H. Introduction to Physical Oceanography; Robert, H., Ed.; Texas A&M University: College Station, TX, USA, 2008; Available online: https://hdl.handle.net/1969.1/160216 (accessed on 21 June 2022).
- Capone, D.G.; Hutchins, D.A. Microbial biogeochemistry of coastal upwelling regimes in a changing ocean. Nat. Geosci. 2013, 6, 711–717. [Google Scholar] [CrossRef]
- Grassle, J.F. Marine Ecosystems. In Encyclopedia of Biodiversity; Levin, S.A., Ed.; Academic Press: Cambridge, MA, USA, 2013; pp. 45–55. [Google Scholar]
- Wolanski, E. Hydrodynamics of mangrove swamps and their coastal waters. Hydrobiologia 1992, 247, 141–161. [Google Scholar] [CrossRef]
- Levasseur, M.E.; Therriault, J.C. Phytoplankton biomass and nutrient dynamics in a tidally induced upwelling: The role of the NO3: SiO4 ratio. Mar. Ecol. Prog. 1987, 39, 87–97. [Google Scholar] [CrossRef]
- Gutiérrez, M.H.; Pantoja, S.; Tejos, E.; Quiñones, R.A. The role of fungi in processing marine organic matter in the upwelling ecosystem off Chile. Mar. Biol. 2011, 158, 205–219. [Google Scholar] [CrossRef]
- Gutiérrez, M.H.; Jara, A.M.; Pantoja, S. Fungal Parasites Infect Marine Diatoms in the Upwelling Ecosystem of the Humboldt Current System off Central Chile. Environ. Microbiol. 2016, 18, 1646–1653. [Google Scholar] [CrossRef] [PubMed]
- Hu, J.; Wang, X.H. Progress on upwelling studies in the China seas. Rev. Geophys. 2016, 54, 653–673. [Google Scholar] [CrossRef]
- Kämpf, J.; Chapman, P. Piers (2016a): Seasonal Wind-Driven Coastal Upwelling Systems. In Upwelling Systems of the World; Springer International Publishing: Cham, Switzerland, 2016; Volume 29, pp. 315–361. [Google Scholar] [CrossRef]
- Correa-Ramirez, M.; Rodriguez-Santana, Á.; Ricaurte-Villota, C.; Paramo, C. The Southern Caribbean upwelling system off Colombia: Water masses and mixing processes. Deep Sea Res. Part I 2020, 155, 103145. [Google Scholar] [CrossRef]
- Varela, R.; Álvarez, I.; Santos, F.; deCastro, M.; Gómez-Gesteira, M. Has upwelling strengthened along worldwide coasts over 1982–2010? Sci. Rep. 2015, 5, 10016. [Google Scholar] [CrossRef]
- Barton, E.D.; Steele, J.; Turekian, K.; Thorpe, S. Canary and Portugal currents. Ocean. Curr. 2001, 1, 330–339. [Google Scholar]
- Gonçalves, M.F.; Esteves, A.C.; Alves, A. Revealing the hidden diversity of marine fungi in Portugal with the description of two novel species, Neoascochyta fuci sp. nov. and Paraconiothyrium salinum sp. nov. Int. J. Syst. Evol. Micr. 2020, 70, 5337–5354. [Google Scholar] [CrossRef]
- Orsi, W.D.; Vuillemin, A.; Coskun, Ö.K.; Rodriguez, P.; Oertel, Y.; Niggemann, J.; Mohrholz, V.; Gomez-Saez, G.V. Carbon assimilating fungi from surface ocean to subseafloor revealed by coupled phylogenetic and stable isotope analysis. ISME J. 2022, 16, 1245–1261. [Google Scholar] [CrossRef]
- Rossi, V.; Feng, M.; Pattiaratchi, C.; Roughan, M.; Waite, A.M. On the factors influencing the development of sporadic upwelling in the Leeuwin Current system. J. Geophys. Res. Oceans 2013, 118, 3608–3621. [Google Scholar] [CrossRef]
- Lutjeharms, J.R.E.; Cooper, J.; Roberts, M. Upwelling at the inshore edge of the Agulhas Current. Cont. Shelf Res. 2000, 20, 737–761. [Google Scholar] [CrossRef]
- Bryden, H.L.; Beal, L.M.; Duncan, L.M. Structure and Transport of the Agulhas Current and Its Temporal Variability. J. Oceanogr. 2005, 61, 479–492. [Google Scholar] [CrossRef]
- deCastro, M.; Sousa, M.C.; Santos, F.; Dias, J.M.; Gómez-Gesteira, M. How will Somali coastal upwelling evolve under future warming scenarios? Sci. Rep. 2016, 6, 30137. [Google Scholar] [CrossRef] [PubMed]
- Ramanantsoa, J.D.; Krug, M.; Penven, P.; Rouault, M.; Gula, J. Coastal upwelling south of Madagascar: Temporal and spatial variability. J. Marine Syst. 2018, 178, 29–37. [Google Scholar] [CrossRef]
- Smitha, B.R.; Sanjeevan, V.N.; Vimalkumar, K.G.; Revichandran, C. On the Upwelling off the Southern Tip and along the West Coast of India. J. Coastal Res. 2008, 24, 95–102. [Google Scholar] [CrossRef]
- Vinayachandran, P.N. Biological response of the sea around Sri Lanka to summer monsoon. Geophys. Res. Lett. 2004, 31. [Google Scholar] [CrossRef]
- De Vos, A.; Pattiaratchi, C.B.; Wijeratne, E.M.S. Surface circulation and upwelling patterns around Sri Lanka. Biogeosciences 2014, 11, 5909–5930. [Google Scholar] [CrossRef]
- McMenamin, M.A.S.; McMenamin, D.L.S. Hypersea and the land ecosystem. BioSystems 1993, 31, 145–153. [Google Scholar] [CrossRef]
- Fuentes, M.E.; Quiñones, R.A. Carbon utilization profile of the filamentous fungal species Fusarium fujikuroi, Penicillium decumbens, and Sarocladium strictum isolated from marine coastal environments. Mycologia 2016, 108, 1069–1081. [Google Scholar] [CrossRef]
- Fuentes, M.E.; Quiñones, R.A.; Gutiérrez, M.H.; Pantoja, S. Effects of temperature and glucose concentration on the growth and respiration of fungal species isolated from a highly productive coastal upwelling ecosystem. Fungal Ecol. 2015, 13, 135–149. [Google Scholar] [CrossRef]
- Cury, J.C.; Araujo, F.V.; Coelho-Souza, S.A.; Peixoto, R.S.; Oliveira, J.A.L.; Santos, H.F.; Dávila, A.M.R.; Rosado, A.S. Microbial diversity of a brazilian coastal region influenced by an upwelling system and anthropogenic activity. PLoS ONE 2021, 6, e16553. [Google Scholar] [CrossRef] [PubMed]
- Hyde, K.D.; Norphanphoun, C.; Chen, J.; Dissanayake, A.J.; Doilom, M.; Hongsanan, S.; Jayawardena, R.S.; Jeewon, R.; Perera, R.H.; Thongbai, B.; et al. Thailand’s amazing diversity: Up to 96% of fungi in northern Thailand may be novel. Fungal Divers. 2018, 93, 215–239. [Google Scholar] [CrossRef]
- Wijayawardene, N.N.; Phillips, A.J.; Pereira, D.S.; Dai, D.Q.; Aptroot, A.; Monteiro, J.S.; Druzhinina, I.S.; Cai, F.; Fan, X.; Selbmann, L.; et al. Forecasting the number of species of asexually reproducing fungi (Ascomycota and Basidiomycota). Fungal Divers. 2022, 13, 463–490. [Google Scholar] [CrossRef]
- Hyde, K.D.; Chethana, K.W.; Jayawardena, R.S.; Luangharn, T.; Calabon, M.S.; Jones, E.B.; Hongsanan, S.; Lumyong, S. The rise of mycology in Asia. Sci. Asia 2020, 46, 1–11. [Google Scholar] [CrossRef]
- Magaña-Dueñas, V.; Cano-Lira, J.F.; Stchigel, A.M. New Dothideomycetes from freshwater habitats in Spain. J. Fungi 2021, 7, 1102. [Google Scholar] [CrossRef] [PubMed]
- Ferrer, A.; Heath, K.D.; Canam, T.; Flores, H.D.; Dalling, J.W. Contribution of fungal and invertebrate communities to wood decay in tropical terrestrial and aquatic habitats. Ecology 2020, 101, e03097. [Google Scholar] [CrossRef] [PubMed]
- Karamchand, K.S.; Sharathchandra, K.; Sridhar, K.R. Diversity of fungal spores in the canopy of two mangrove tree species of southwest India. Int. J. Agric. Technol. 2021, 17, 2097–2110. [Google Scholar]
- Xiao, R.; Guo, Y.; Zhang, M.; Pan, W.; Wang, J.J. Stronger network connectivity with lower diversity of soil fungal community was presented in coastal marshes after sixteen years of freshwater restoration. Sci. Total Environ. 2020, 744, 140623. [Google Scholar] [CrossRef]
- Ramírez, F.; Afán, I.; Davis, L.S.; Chiaradia, A. Climate impacts on global hot spots of marine biodiversity. Sci. Adv. 2017, 3, e1601198. [Google Scholar] [CrossRef] [PubMed]
- Bass, D.; Howe, A.; Brown, N.; Barton, H.; Demidova, M.; Michelle, H.; Li, L.; Sanders, H.; Watkinson, S.C.; Willcock, S.; et al. Yeast forms dominate fungal diversity in the deep oceans. Proc. Biol. Sci. 2007, 274, 3069–3077. [Google Scholar] [CrossRef]
- Panzer, K.; Yilmaz, P.; Weiß, M.; Reich, L.; Richter, M.; Wiese, J.; Schmalijohann, R.; Labes, A.; Imhoff, J.F.; Glockner, F.O.; et al. Identification of habitat-specific biomes of aquatic fungal communities using a comprehensive nearly full-length 18S rRNA dataset enriched with contextual data. PLoS ONE 2015, 10, e0134377. [Google Scholar] [CrossRef] [PubMed]
- Margulies, M.; Egholm, M.; Altman, W.E.; Attiya, S.; Bader, J.S.; Bemben, L.A.; Berka, J.; Braverman, M.S.; Chen, Y.-J.; Chen, Z.; et al. Genome sequencing in microfabricated high-density picolitre reactors. Nature 2005, 437, 376–380. [Google Scholar] [CrossRef] [PubMed]
- Shendure, J.; Porreca, G.J.; Reppas, N.B.; Lin, X.; McCutcheon, J.P.; Rosenbaum, A.M.; Wang, M.D.; Zhang, K.; Mitra, R.D.; Church, G.M. Accurate Multiplex Polony Sequencing of an evolved bacterial genome. Science 2005, 309, 1728–1732. [Google Scholar] [CrossRef]
- Schuster, S.C. Next-generation sequencing transforms today’s biology. Nat. Methods 2008, 5, 16–18. [Google Scholar] [CrossRef] [PubMed]
- Shendure, J.; Ji, H. Next-generation DNA sequencing. Nat. Biotechnol. 2008, 26, 1135–1145. [Google Scholar] [CrossRef]
- Thakur, N.; Shirkot, P.; Pandey, H.; Thakur, K.; Kumar, V.; Rachappanavar, K.T. Next generation sequencing—Techniques and its applications. J. Pharmacogn. Phytochem. 2018, 7, 1316–1320. [Google Scholar]
- Shokralla, S.; Spall, J.L.; Gibson, J.F.; Hajibabaei, M. Next-generation sequencing technologies for environmental DNA research. Mol. Ecol. 2012, 21, 1794–1805. [Google Scholar] [CrossRef]
- Loganathachetti, D.S.; Poosakkannu, A.; Muthuraman, S. Fungal community assemblage of different soil compartments in mangrove ecosystem. Sci. Rep. 2017, 7, 8560. [Google Scholar] [CrossRef]
- Lendemer, J.C.; Keepers, K.G.; Tripp, E.A.; Pogoda, C.S.; McCain, C.M.; Kane, N.C. A taxonomically broad metagenomic survey of 339 species spanning 57 families suggests Cystobasidiomycete yeasts are not ubiquitous across all lichens. Am. J. Bot. 2019, 106, 1090–1095. [Google Scholar] [CrossRef]
- Wu, B.; Hussain, M.; Zhang, W.; Stadler, M.; Liu, X.Z.; Xing, M. Current insight into fungal species diversity and perspective on naming the environmental DNA sequences of fungi. Mycology 2019, 10, 127–140. [Google Scholar] [CrossRef]
- Suwannarach, N.; Kumla, J.; In-on, A.; Lumyong, S. Soil metabarcoding offers a new tool for the investigation and hunting of truffles in northern Thailand. J. Fungi 2021, 7, 293. [Google Scholar] [CrossRef] [PubMed]
- Xu, J. Fungal DNA barcoding1. Genome 2016, 59, 913–932. [Google Scholar] [CrossRef] [PubMed]
- Bellemain, E.; Davey, M.; Kauserud, H.; Epp, L.S.; Boessenkool, S.; Coissac, E.; Geml, J.; Edwards, M.; Willerslev, E.; Gussarova, G.; et al. Fungal palaeodiversity revealed using high-throughput metabarcoding of ancient DNA from arctic permafrost. Environ. Microbiol. 2012, 15, 1176–1189. [Google Scholar] [CrossRef] [PubMed]
- Schoch, C.L.; Seifert, K.A.; Huhndorf, S.; Robert, V.; Spouge, J.L.; Levesque, C.A.; Chen, W. Fungal barcoding consortium; fungal barcoding consortium author list. Nuclear ribosomal internal transcribed spacer (ITS) region as a universal DNA barcode marker for fungi. Proc. Natl. Acad. Sci. USA 2012, 109, 6241–6246. [Google Scholar] [CrossRef]
- Bokulich, N.A.; Mills, D.A. Next-generation approaches to the microbial ecology of food fermentations. BMB Rep. 2012, 45, 377–389. [Google Scholar] [CrossRef] [PubMed]
- Hajibabaei, M. The golden age of DNA metasystematics. Trends Genet. 2012, 28, 535–537. [Google Scholar] [CrossRef]
- Tekpinar, A.D.; Kalmer, A. Utility of various molecular markers in fungal identification and phylogeny. Nova Hedwig. 2019, 109, 187–224. [Google Scholar] [CrossRef]
- Zepeda Mendoza, M.L.; Sicheritz-Ponten, T.; Gilbert, M.T. Environmental genes and genomes: Understanding the differences and challenges in the approaches and software for their analyses. Brief. Bioinform. 2015, 16, 745–758. [Google Scholar] [CrossRef]
- Tedersoo, L.; Anslan, S.; Bahram, M.; Kõljalg, U.; Abarenkov, K. Identifying the ‘unidentified’fungi: A global-scale long-read third-generation sequencing approach. Fungal Divers. 2020, 103, 273–293. [Google Scholar] [CrossRef]
- Tedersoo, L.; Bahram, M.; Puusepp, R.; Nilsson, R.H.; James, T.Y. Novel soil-inhabiting clades fill gaps in the fungal tree of life. Microbiome 2017, 5, 42. [Google Scholar] [CrossRef]
- Zhang, T.; Wang, Z.; Lv, X.; Li, Y.; Zhuang, L. High-throughput sequencing reveals the diversity and community structure of rhizosphere fungi of Ferula Sinkiangensis at different soil depths. Sci. Rep. 2019, 9, 6558. [Google Scholar] [CrossRef] [PubMed]
- Baldrian, P.; Větrovský, T.; Lepinay, C.; Kohout, K. High-throughput sequencing view on the magnitude of global fungal diversity. Fungal Divers. 2022, 114, 539–547. [Google Scholar] [CrossRef]
- Raghukumar, C.; Damare, S.R.; Singh, P. A review on deep-sea fungi occurrence, diversity and adaptations. Bot. Mar. 2010, 53, 479–492. [Google Scholar] [CrossRef]
- Amend, A.S.; Barshis, D.J.; Oliver, T.A. Coral-associated marine fungi form novel lineages and heterogeneous assemblages. ISME J. 2012, 6, 1291–1301. [Google Scholar] [CrossRef] [PubMed]
- Nagano, Y.; Miura, T.; Nishi, S.; Lima, A.O.; Nakayama, C.; Pellizari, V.H.; Fujikura, K. Fungal diversity in deep-sea sediments associated with asphalt seeps at the Sao Paulo Plateau. Deep. Sea Res. Part II Top. Stud. Oceanogr. 2017, 146, 59–67. [Google Scholar] [CrossRef]
- Jobard, M.; Rasconi, S.; Sime-Ngando, T. Diversity and functions of microscopic fungi: A missing component in pelagic food webs. Aquat. Sci. 2010, 72, 255–268. [Google Scholar] [CrossRef]
- Song, P.; Tanabe, S.; Yi, R.; Kagami, M.; Liu, X.; Ban, S. Fungal community structure at pelagic and littoral sites in Lake Biwa determined with high-throughput sequencing. Limnology 2018, 19, 241–251. [Google Scholar] [CrossRef]
- Xu, W.; Gao, Y.H.; Gong, L.F.; Li, M.; Pang, K.L.; Luo, Z.H. Fungal diversity in the deep-sea hadal sediments of the Yap Trench by cultivation and high throughput sequencing methods based on ITS rRNA gene. Deep. Sea Res. Part I Oceanogr. Res. Pap. 2019, 145, 125–136. [Google Scholar] [CrossRef]
- Vohník, M.; Borovec, O.; Kolaříková, Z.; Sudová, R.; Réblová, M. Extensive sampling and high-throughput sequencing reveal Posidoniomyces atricolor gen. et sp. nov. (Aigialaceae, Pleosporales) as the dominant root mycobiont of the dominant Mediterranean seagrass Posidonia oceanica. MycoKeys 2019, 55, 59–86. [Google Scholar] [CrossRef]
- Zheng, H.; Qiao, M.; Xu, J.; Yu, Z. Culture-based and culture-independent assessments of endophytic fungal diversity in aquatic plants in Southwest China. Front. Fungal Bio. 2021, 2, 692549. [Google Scholar] [CrossRef]
- Roth, F.J.; Orpurt, P.A.; Ahearn, D.J. Occurrence and distribution of fungi in a subtropical marine environment. Can. J. Bot. 1964, 42, 375–383. [Google Scholar] [CrossRef]
- Kohlmeyer, J. Deterioration of wood by marine fungi in the deep sea. Mater. Perform. Deep. Sea Spec. Tech. Publ. 1969, 445, 20–30. [Google Scholar]
- Kohlmeyer, J. New-Genera and Species of Higher Fungi from Deep-Sea (1615-5315 M)-(1). Rev. Mycol. 1977, 41, 189–206. [Google Scholar]
- Dupont, J.; Magnin, S.; Rousseau, F.; Zbinden, M.; Frebourg, G.; Samadi, S.; de Forges, B.R.; Jones, E.B. Molecular and ultrastructural characterization of two ascomycetes found on sunken wood off Vanuatu islands in the deep Pacific Ocean. Mycol. Res. 2009, 113, 1351–1364. [Google Scholar] [CrossRef]
- Dupont, J.; Schwabe, E. First evidence of the deep-sea fungus Oceanitis scuticella Kohlmeyer (Halosphaeriaceae, Ascomycota) from the Northern Hemisphere. Bot. Mar. 2016, 59, 275–282. [Google Scholar] [CrossRef]
- Nagano, Y.; Fujiwara, Y.; Nishimoto, A.; Haga, T.; Fujikura, K. Deep-sea endemic fungi? The discovery of Alisea longicolla from artificially immersed wood in deep sea off the Nansei Islands, Japan. Mycoscience 2019, 60, 228–231. [Google Scholar] [CrossRef]
- Nagahama, T.; Hamamoto, M.; Nakase, T.; Horikoshi, K. Rhodotorula lamellibrachii sp nov., a new yeast species from a tubeworm collected at the deep-sea floor in Sagami Bay and its phylogenetic analysis. Antonie Leeuwenhoek Int. J. Gen. Mol. Microbiol. 2001, 80, 317–323. [Google Scholar] [CrossRef] [PubMed]
- Nagahama, T.; Hamamoto, M.; Nakase, T.; Takaki, Y.; Horikoshi, K. Cryptococcus surugaensis sp nov., a novel yeast species from sediment collected on the deep-sea floor of Suruga Bay. Int. J. Syst. Evol. Micr. 2003, 53, 2095–2098. [Google Scholar] [CrossRef] [PubMed][Green Version]
- Raghlukumar, C.; Raghukumar, S.; Sheelu, G.; Gupta, S.M.; Nath, B.N.; Rao, B.R. Buried in time: Culturable fungi in a deep-sea sediment core from the Chagos Trench, Indian Ocean. Deep-Sea Res. Part I 2004, 51, 1759–1768. [Google Scholar] [CrossRef]
- Damare, S.; Raghukumar, C.; Raghukumar, S. Fungi in deep-sea sediments of the Central Indian Basin. Deep-Sea Res. Part I 2006, 53, 14–27. [Google Scholar] [CrossRef]
- Burgaud, G.; Le Calvez, T.; Arzur, D.; Vandenkoornhuyse, P.; Barbier, G. Diversity of culturable marine filamentous fungi from deep-sea hydrothermal vents. Environ. Microbiol. 2009, 11, 1588–1600. [Google Scholar] [CrossRef] [PubMed]
- Burgaud, G.; Arzur, D.; Sampaio, J.P.; Barbier, G. Candida oceani sp. nov., a novel yeast isolated from a Mid-Atlantic Ridge hydrothermal vent (-2300 meters). Antonie Leeuwenhoek 2011, 100, 75–82. [Google Scholar] [CrossRef] [PubMed]
- Singh, P.; Raghukumar, C.; Verma, P.; Shouche, Y. Phylogenetic diversity of culturable fungi from the deep-sea sediments of the Central Indian Basin and their growth characteristics. Fungal Divers. 2010, 40, 89–102. [Google Scholar] [CrossRef]
- Zhang, L.; Xi, L.; Qiu, D.; Song, L.; Dai, X.; Ruan, J.; Huang, Y. Cellulomonas marina sp. nov., isolated from deep-sea water. Int. J. Syst. Evol. Microbiol. 2013, 63, 3014–3018. [Google Scholar] [CrossRef] [PubMed]
- Manohar, C.S.; Menezes, L.D.; Ramasamy, K.P.; Meena, R.M. Phylogenetic analyses and nitrate-reducing activity of fungal cultures isolated from the permanent, oceanic oxygen minimum zone of the Arabian Sea. Can. J. Microbiol. 2015, 61, 217–226. [Google Scholar] [CrossRef] [PubMed]
- Redou, V.; Navarri, M.; Meslet-Cladiere, L.; Barbier, G.; Burgaud, G. Species richness and adaptation of marine fungi from deep-subseafloor sediments. Appl. Environ. Microbiol. 2015, 81, 3571–3583. [Google Scholar] [CrossRef]
- Nagano, Y.; Konishi, M.; Nagahama, T.; Kubota, T.; Abe, F.; Hatada, Y. Retrieval of deeply buried culturable fungi in marine subsurface sediments, Suruga-Bay, Japan. Fungal Ecol. 2016, 20, 256–259. [Google Scholar] [CrossRef]
- Wei, X.; Guo, S.S.; Gong, L.F.; He, G.Y.; Pang, K.L.; Luo, Z.H. Cultivable Fungal Diversity in Deep-Sea Sediment of the East Pacific Ocean. Geomicrobiol. J. 2018, 35, 790–797. [Google Scholar] [CrossRef]
- Gao, Y.; Du, X.; Xu, W.; Fan, R.; Zhang, X.; Yang, S.; Chen, X.; Lv, J.; Luo, Z. Fungal Diversity in Deep Sea Sediments from East Yap Trench and Their Denitrification Potential. Geomicrobiol. J. 2020, 37, 848–858. [Google Scholar] [CrossRef]
- Ogaki, M.B.; Coelho, L.C.; Vieira, R.; Neto, A.A.; Zani, C.L.; Alves, T.M.A.; Junior, P.A.S.; Murta, S.M.F.; Barbosa, E.C.; Oliveira, J.G.; et al. Cultivable fungi present in deep-sea sediments of antarctica: Taxonomy, diversity, and bioprospecting of bioactive compounds. Extremophiles 2020, 24, 227–238. [Google Scholar] [CrossRef]
- Keeler, E.; Burgaud, G.; Teske, A.; Beaudoin, D.; Mehiri, M.; Dayras, M.; Cassand, J.; Edgcomb, V. Deep-sea hydrothermal vent sediments reveal diverse fungi with antibacterial activities. FEMS Microbiol. Ecol. 2021, 97, 103. [Google Scholar] [CrossRef]
- Marchese, P.; Garzoli, L.; Young, R.; Allcock, L.; Barry, F.; Tuohy, M.; Murphy, M. Fungi populate deep-sea coral gardens as well as marine sediments in the Irish Atlantic Ocean. Environ. Microbiol. 2021, 23, 4168–4184. [Google Scholar] [CrossRef]
- Vargas-Gastelum, L.; Riquelme, M. The Mycobiota of the Deep Sea: What Omics Can Offer. Life 2020, 10, 292. [Google Scholar] [CrossRef] [PubMed]
- Ogaki, M.B.; Pinto, O.H.B.; Vieira, R.; Neto, A.A.; Convey, P.; Carvalho-Silva, M.; Rosa, C.A.; Camara, P.; Rosa, L.H. Fungi Present in Antarctic Deep-Sea Sediments Assessed Using DNA Metabarcoding. Microb. Ecol. 2021, 82, 157–164. [Google Scholar] [CrossRef] [PubMed]
- Nagano, Y.; Nagahama, T. Fungal diversity in deep-sea extreme environments. Fungal Ecol. 2012, 5, 463–471. [Google Scholar] [CrossRef]
- Barone, G.; Rastelli, E.; Corinaldesi, C.; Tangherlini, M.; Danovaro, R.; Dell’Anno, A. Benthic deep-sea fungi in submarine canyons of the Mediterranean Sea. Prog. Oceanogr. 2018, 168, 57–64. [Google Scholar] [CrossRef]
- Nagano, Y.; Miura, T.; Tsubouchi, T.; Lima, A.O.; Kawato, M.; Fujiwara, Y.; Fujikura, K. Cryptic fungal diversity revealed in deep-sea sediments associated with whale-fall chemosynthetic ecosystems. Mycology 2020, 11, 263–278. [Google Scholar] [CrossRef]
- Nilsson, R.H.; Ryberg, M.; Abarenkov, K.; Sjökvist, E.; Kristiansson, E. The ITS region as a target for characterization of fungal communities using emerging sequencing technologies. FEMS Microbiol. Lett. 2009, 296, 97–101. [Google Scholar] [CrossRef]
- Nagano, Y.; Nagahama, T.; Hatada, Y.; Nunoura, T.; Takami, H.; Miyazaki, J.; Takai, K.; Horikoshi, K. Fungal diversity in deep-sea sediments—the presence of novel fungal groups. Fungal Ecol. 2010, 3, 316–325. [Google Scholar] [CrossRef]
- Nagahama, T.; Takahashi, E.; Nagano, Y.; Abdel-Wahab, M.A.; Miyazaki, M. Molecular evidence that deep-branching fungi are major fungal components in deep-sea methane cold-seep sediments. Environ. Microbiol. 2011, 13, 2359–2370. [Google Scholar] [CrossRef] [PubMed]
- Takishita, K.; Miyake, H.; Kawato, M.; Maruyama, T. Genetic diversity of microbial eukaryotes in anoxic sediment around fumaroles on a submarine caldera floor based on the small-subunit rDNA phylogeny. Extremophiles 2005, 9, 185–196. [Google Scholar] [CrossRef] [PubMed]
- Feng, L.; Song, Q.; Jiang, Q.; Li, Z. The Horizontal and Vertical Distribution of Deep-Sea Sediments Fungal Community in the South China Sea. Front. Mar. Sci. 2021, 8, 592784. [Google Scholar] [CrossRef]
- Yang, S.; Xu, W.; Gao, Y.; Chen, X.; Luo, Z.H. Fungal diversity in deep-sea sediments from Magellan seamounts environment of the western Pacific revealed by high-throughput Illumina sequencing. J. Microbiol. 2020, 58, 841–852. [Google Scholar] [CrossRef] [PubMed]
- Luo, Y.; Wei, X.; Yang, S.; Gao, Y.H.; Luo, Z.H. Fungal diversity in deep-sea sediments from the Magellan seamounts as revealed by a metabarcoding approach targeting the ITS2 regions. Mycology 2020, 11, 214–229. [Google Scholar] [CrossRef] [PubMed]
- Vargas-Gastelum, L.; Chong-Robles, J.; Lago-Leston, A.; Darcy, J.L.; Amend, A.S.; Riquelme, M. Targeted ITS1 sequencing unravels the mycodiversity of deep-sea sediments from the Gulf of Mexico. Environ. Microbiol. 2019, 21, 4046–4061. [Google Scholar] [CrossRef] [PubMed]
- Wang, Z.P.; Liu, Z.Z.; Wang, Y.L.; Bi, W.H.; Liu, L.; Wang, H.Y.; Zheng, Y.; Zhang, L.L.; Hu, S.G.; Xu, S.S.; et al. Fungal community analysis in seawater of the Mariana Trench as estimated by Illumina HiSeq. RSC Adv. 2019, 9, 6956–6964. [Google Scholar] [CrossRef] [PubMed]
- Frisvad, J.C.; Andersen, B.; Thrane, U. The use of secondary metabolite profiling in chemotaxonomy of filamentous fungi. Mycol. Res. 2008, 112, 231–240. [Google Scholar] [CrossRef]
- Lambert, C.; Wendt, L.; Hladki, A.I.; Stadler, M.; Sir, E.B. Hypomontagnella (Hypoxylaceae): A new genus segregated from Hypoxylon by a polyphasic taxonomic approach. Mycol. Prog. 2019, 18, 187–201. [Google Scholar] [CrossRef]
- Kelman, M.J.; Renaud, J.B.; Seifert, K.A.; Mack, J.; Yeung, K.K.C.; Sumarah, M.W. Chemotaxonomic profiling of Canadian Alternaria populations using high-resolution mass spectrometry. Metabolites 2020, 10, 238. [Google Scholar] [CrossRef]
- Kim, W.; Peever, T.L.; Park, J.J.; Park, C.M.; Gang, D.R.; Xian, M.; Davidson, J.A.; Infantino, A.; Kaiser, W.J.; Chen, W. Use of metabolomics for the chemotaxonomy of legume-associated Ascochyta and allied genera. Sci. Rep. 2016, 6, 20192. [Google Scholar] [CrossRef]
- Tawfike, A.F.; Tate, R.; Abbott, G.; Young, L.; Viegelmann, C.; Schumacher, M.; Diederich, M.; Edrada-Ebel, R. Metabolomic Tools to Assess the Chemistry and Bioactivity of Endophytic Aspergillus Strain. Chem. Biodivers. 2017, 14, e1700040. [Google Scholar] [CrossRef] [PubMed]
- Maciá-Vicente, J.G.; Shi, Y.N.; Cheikh-Ali, Z.; Grün, P.; Glynou, K.; Kia, S.H.; Piepenbring, M.; Bode, H.B. Metabolomics-based chemotaxonomy of root endophytic fungi for natural products discovery. Environ. Microbiol. 2018, 20, 1253–1270. [Google Scholar] [CrossRef] [PubMed]
- Uhlig, S.; Rangel-Huerta, O.D.; Divon, H.H.; Rolén, E.; Pauchon, K.; Sumarah, M.W.; Vrålstad, T.; Renaud, J.B. Unraveling the ergot alkaloid and indole diterpenoid metabolome in the Claviceps purpurea species complex using LC-HRMS/MS Diagnostic Fragmentation Filtering. J. Agric. Food Chem. 2021, 69, 7137–7148. [Google Scholar] [CrossRef]
- Himmelreich, U.; Somorjai, R.L.; Dolenko, B.; Daniel, H.M.; Sorrell, T.C. A rapid screening test to distinguish between Candida albicans and Candida dubliniensis using NMR spectroscopy. FEMS Microbiol. Lett. 2005, 251, 327–332. [Google Scholar] [CrossRef] [PubMed][Green Version]
- Kang, D.J.; Kim, J.Y.; Choi, J.N.; Liu, K.H.; Lee, C.H. Chemotaxonomy of Trichoderma spp. using mass spectrometry-based metabolite profiling. J. Microbio. Biotechn. 2011, 21, 5–13. [Google Scholar] [CrossRef]
- Aliferis, K.A.; Cubeta, M.A.; Jabaji, S. Chemotaxonomy of fungi in the Rhizoctonia solani species complex performing GC/MS metabolite profiling. Metabolomics 2013, 9, 159–169. [Google Scholar] [CrossRef]
- Wang, H.N.; Sun, S.S.; Liu, M.Z.; Yan, M.C.; Liu, Y.F.; Zhu, Z.; Zhang, Z. Natural bioactive compounds from marine fungi (2017–2020). J. Asian Nat. Prod. Res. 2022, 24, 203–230. [Google Scholar] [CrossRef]
- Ortega, H.E.; Torres-Mendoza, D.; Caballero, E.Z.; Cubilla-Rios, L. Structurally uncommon secondary metabolites derived from endophytic fungi. J. Fungi 2021, 7, 570. [Google Scholar] [CrossRef]
- Ul Hassan, S.S.; Ishaq, M.; Zhang, W.D.; Jin, H.Z. An overview of the mechanisms of marine fungi-derived anti-inflammatory and anti-tumor agents and their novel role in drug targeting. Curr. Pharm. Des. 2021, 27, 2605–2614. [Google Scholar] [CrossRef]
- Vohník, M.; Borovec, O.; Kolařík, M. Communities of cultivable root mycobionts of the seagrass Posidonia oceanica in the northwest Mediterranean Sea are dominated by a hitherto undescribed pleosporalean dark septate endophyte. Microb. Ecol. 2016, 71, 442–451. [Google Scholar] [CrossRef]
- Ettinger, C.L.; Vann, L.E.; Eisen, J.A. Global diversity and biogeography of the Zostera marina mycobiome. Appl. Environ. Microb. 2021, 87, e0279520. [Google Scholar] [CrossRef] [PubMed]
- Rämä, T.; Nordén, J.; Davey, M.L.; Mathiassen, G.H.; Spatafora, J.W.; Kauserud, H. Fungi ahoy! Diversity on marine wooden substrata in the high North. Fungal Ecol. 2014, 8, 46–58. [Google Scholar] [CrossRef]
- Hawksworth, D.L. The fungal dimension of biodiversity: Magnitude, significance, and conservation. Mycol. Res. 1991, 95, 641–655. [Google Scholar] [CrossRef]
- He, L.; Wang, Q.; Wang, Z.; Wang, F.; Sun, S.; Liu, X. Eukaryotic diversity based on high-throughput 18S rRNA sequencing and its relationship with environmental factors in a Salt Lake in tibet, china. Water 2022, 14, 2724. [Google Scholar] [CrossRef]
- Pang, K.L.; Shauddin, S.S.; Alias, S.A.; Nor, N.A.M.; Awaluddin, H.H. Diversity and abundance of lignicolous marine fungi form the east and west coasts of Peninsular Malaysia and Sabah (Borneo Island). Bot. Mar. 2010, 53, 515–523. [Google Scholar] [CrossRef]
- Hawksworth, D.L.; Rossman, A.Y. Where are all the undescribed fungi? Phytopathology 1997, 87, 888–891. [Google Scholar] [CrossRef]
- Hibbett, D.S.; Ohman, A.; Glotzer, D.; Nuhn, M.; Kirk, P.; Nilsson, R.H. Progress in molecular and morphological taxon discovery in Fungi and options for formal classification of environmental sequences. Fungal Biol. Rev. 2011, 25, 38–47. [Google Scholar] [CrossRef]

Publisher’s Note: MDPI stays neutral with regard to jurisdictional claims in published maps and institutional affiliations. |
© 2022 by the authors. Licensee MDPI, Basel, Switzerland. This article is an open access article distributed under the terms and conditions of the Creative Commons Attribution (CC BY) license (https://creativecommons.org/licenses/by/4.0/).
Share and Cite
Wijayawardene, N.N.; Dai, D.-Q.; Jayasinghe, P.K.; Gunasekara, S.S.; Nagano, Y.; Tibpromma, S.; Suwannarach, N.; Boonyuen, N. Ecological and Oceanographic Perspectives in Future Marine Fungal Taxonomy. J. Fungi 2022, 8, 1141. https://doi.org/10.3390/jof8111141
Wijayawardene NN, Dai D-Q, Jayasinghe PK, Gunasekara SS, Nagano Y, Tibpromma S, Suwannarach N, Boonyuen N. Ecological and Oceanographic Perspectives in Future Marine Fungal Taxonomy. Journal of Fungi. 2022; 8(11):1141. https://doi.org/10.3390/jof8111141
Chicago/Turabian StyleWijayawardene, Nalin N., Don-Qin Dai, Prabath K. Jayasinghe, Sudheera S. Gunasekara, Yuriko Nagano, Saowaluck Tibpromma, Nakarin Suwannarach, and Nattawut Boonyuen. 2022. "Ecological and Oceanographic Perspectives in Future Marine Fungal Taxonomy" Journal of Fungi 8, no. 11: 1141. https://doi.org/10.3390/jof8111141
APA StyleWijayawardene, N. N., Dai, D.-Q., Jayasinghe, P. K., Gunasekara, S. S., Nagano, Y., Tibpromma, S., Suwannarach, N., & Boonyuen, N. (2022). Ecological and Oceanographic Perspectives in Future Marine Fungal Taxonomy. Journal of Fungi, 8(11), 1141. https://doi.org/10.3390/jof8111141










